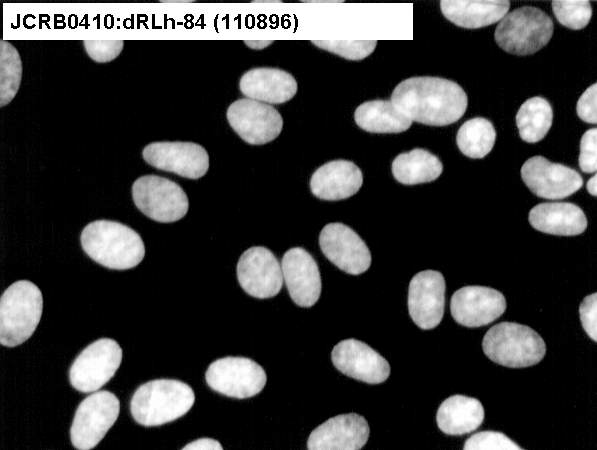

JCRB0410 dRLh-84
細胞情報
細胞種類:一般細胞 (細胞分譲手数料はこちら)
| 細胞番号(JCRB) | JCRB0410 | 細胞名 | dRLh-84 |
|---|---|---|---|
| 生物種(日本語) | ラット | 組織名(日本語) | 肝臓 |
| コメント(日本語) | 肝細胞がん, (Donryu rat) | プロフィール | hepatoma, (Donryu rat) |
| 別名 | dRLh-84 | 動物名 | rat |
| 系統名 | Donryu | 学名・属名 | Rattus |
| 学名・種小名 | norvegicus | 性別 | |
| 年齢・月齢 | 細胞識別情報 | ||
| (癌)原発組織名 | liver | 病歴情報 | |
| 転移の有無(Y/N) | (癌)転移組織名 | ||
| 遺伝的性質 | hepatoma | 細胞寿命 | |
| クライシスPDL | 形態 | ||
| 一般性状 | hepatoma | 細胞分類 | |
| 細胞樹立者名 | Sato,J. | 細胞寄託者 | Sato,J. |
| 分譲時制限 | コメント | Cell to cell connection is weak. Highly malignant. Easy to handle. Possibly applicable to the screening of anti-cancer reagents. | |
| 入手年 | 培養培地 | Eagle's minimal essential medium with 10% fetal bovine serum. | |
| 継代方法 | Cells are treated with 0.2% trypsin alone and subculture once a week. | 継代時細胞数 | 5x10^4 cells/ml |
| 人種 | 炭酸ガス濃度 | 5 % | |
| 採取組織名 | liver | 組織型 |
| ウイルスDNA・RNA検出検査 (Detection of virus genome fragment by Real-time PCR) | |||||||||
|---|---|---|---|---|---|---|---|---|---|
| ウイルスDNA 検出検査 |
not tested | ウイルスRNA 検出検査 |
not tested | ||||||
| Reference | |
|---|---|
| Pubmed id:2914912 | Rat pyruvate kinase M gene. Its complete structure and characterization of the 5'-flanking region. Takenaka M,Noguchi T,Inoue H,Yamada K,Matsuda T,Tanaka T J Biol Chem. 1989 Feb 5;264(4):2363-7 |
| Pubmed id:4955999 | Carcinogenesis in tissue culture. VI. Tissue culture of liver cells from DAB-feeding rats. Sato J,Yabe T Jpn J Exp Med. 1965 Dec;35(6):491-511 |
| Images |
|---|
![]() ![]() ![]() ![]() |